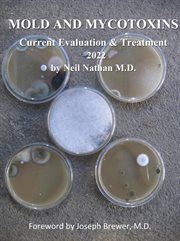
Mold and mycotoxins: current evaluation and treatment 2022 cover image

Details
PUBLISHED
Made available through hoopla
DESCRIPTION
1 online resource
ISBN/ISSN
LANGUAGE
NOTES
It is estimated by some experts that mold toxicity is currently affecting, some extent, up to 10 million Americans. Most of those individuals are unaware of the existence of this condition and, unfortunately, most medical practitioners are not aware of it either. This had led to the unfortunate situation in which patients with mold toxicity (who often present with a wide array of symptoms including fatigue, cognitive impairment, anxiety, depression, shortness of breath, chronic sinus symptoms, abdominal pain, diarrhea, constipation, cramping, headaches, muscle and joint pain, and paresthesias, amongst others) are dismissed by their physicians and families as psychogenic. This leads to incorrect diagnoses and treatments and social isolation, which becomes tragic since this condition can be treated when properly diagnosed. This new book is an update of my original e-book, published in 2016, which began the process of bringing these issues to light. With six more years of research and clinical experience, I am updating what we know about all aspects of mold toxicity to make this subject as accessible and current as possible. Since many of my patients have some degree of cognitive impairment as a part of their illness, I have attempted to make this as concise and readable as possible, so that they, and their families can get a quick overview of the subject of mold toxicity to begin to understand this illness and move forward with healing. For those who wish to delve into more detail, I encourage them to read (also available in audio for those for whom reading has become difficult) my book "Toxic: Heal Your Body from Mold Toxicity, Lyme Disease, Multiple Chemical Sensitivities and Chronic Environmental Illness". In this e-book we will discuss a little of how we began to understand mold toxicity as a common medical condition, and then go into detail about the symptoms with which it presents, how to diagnose it, and how to approach treatment. Since mold toxicity commonly triggers several other medical conditions, such as limbic dysfunction, vagal nerve dysfunction, and mast cell activation, all of which contribute to creating a patient who is exceptionally sensitive and reactive to foods, medications and chemicals, these conditions will also be discussed. It is hoped that readers will come to realize that their symptoms are very real, and that medical treatment can help to restore complete health once the diagnosis has been made
Mode of access: World Wide Web